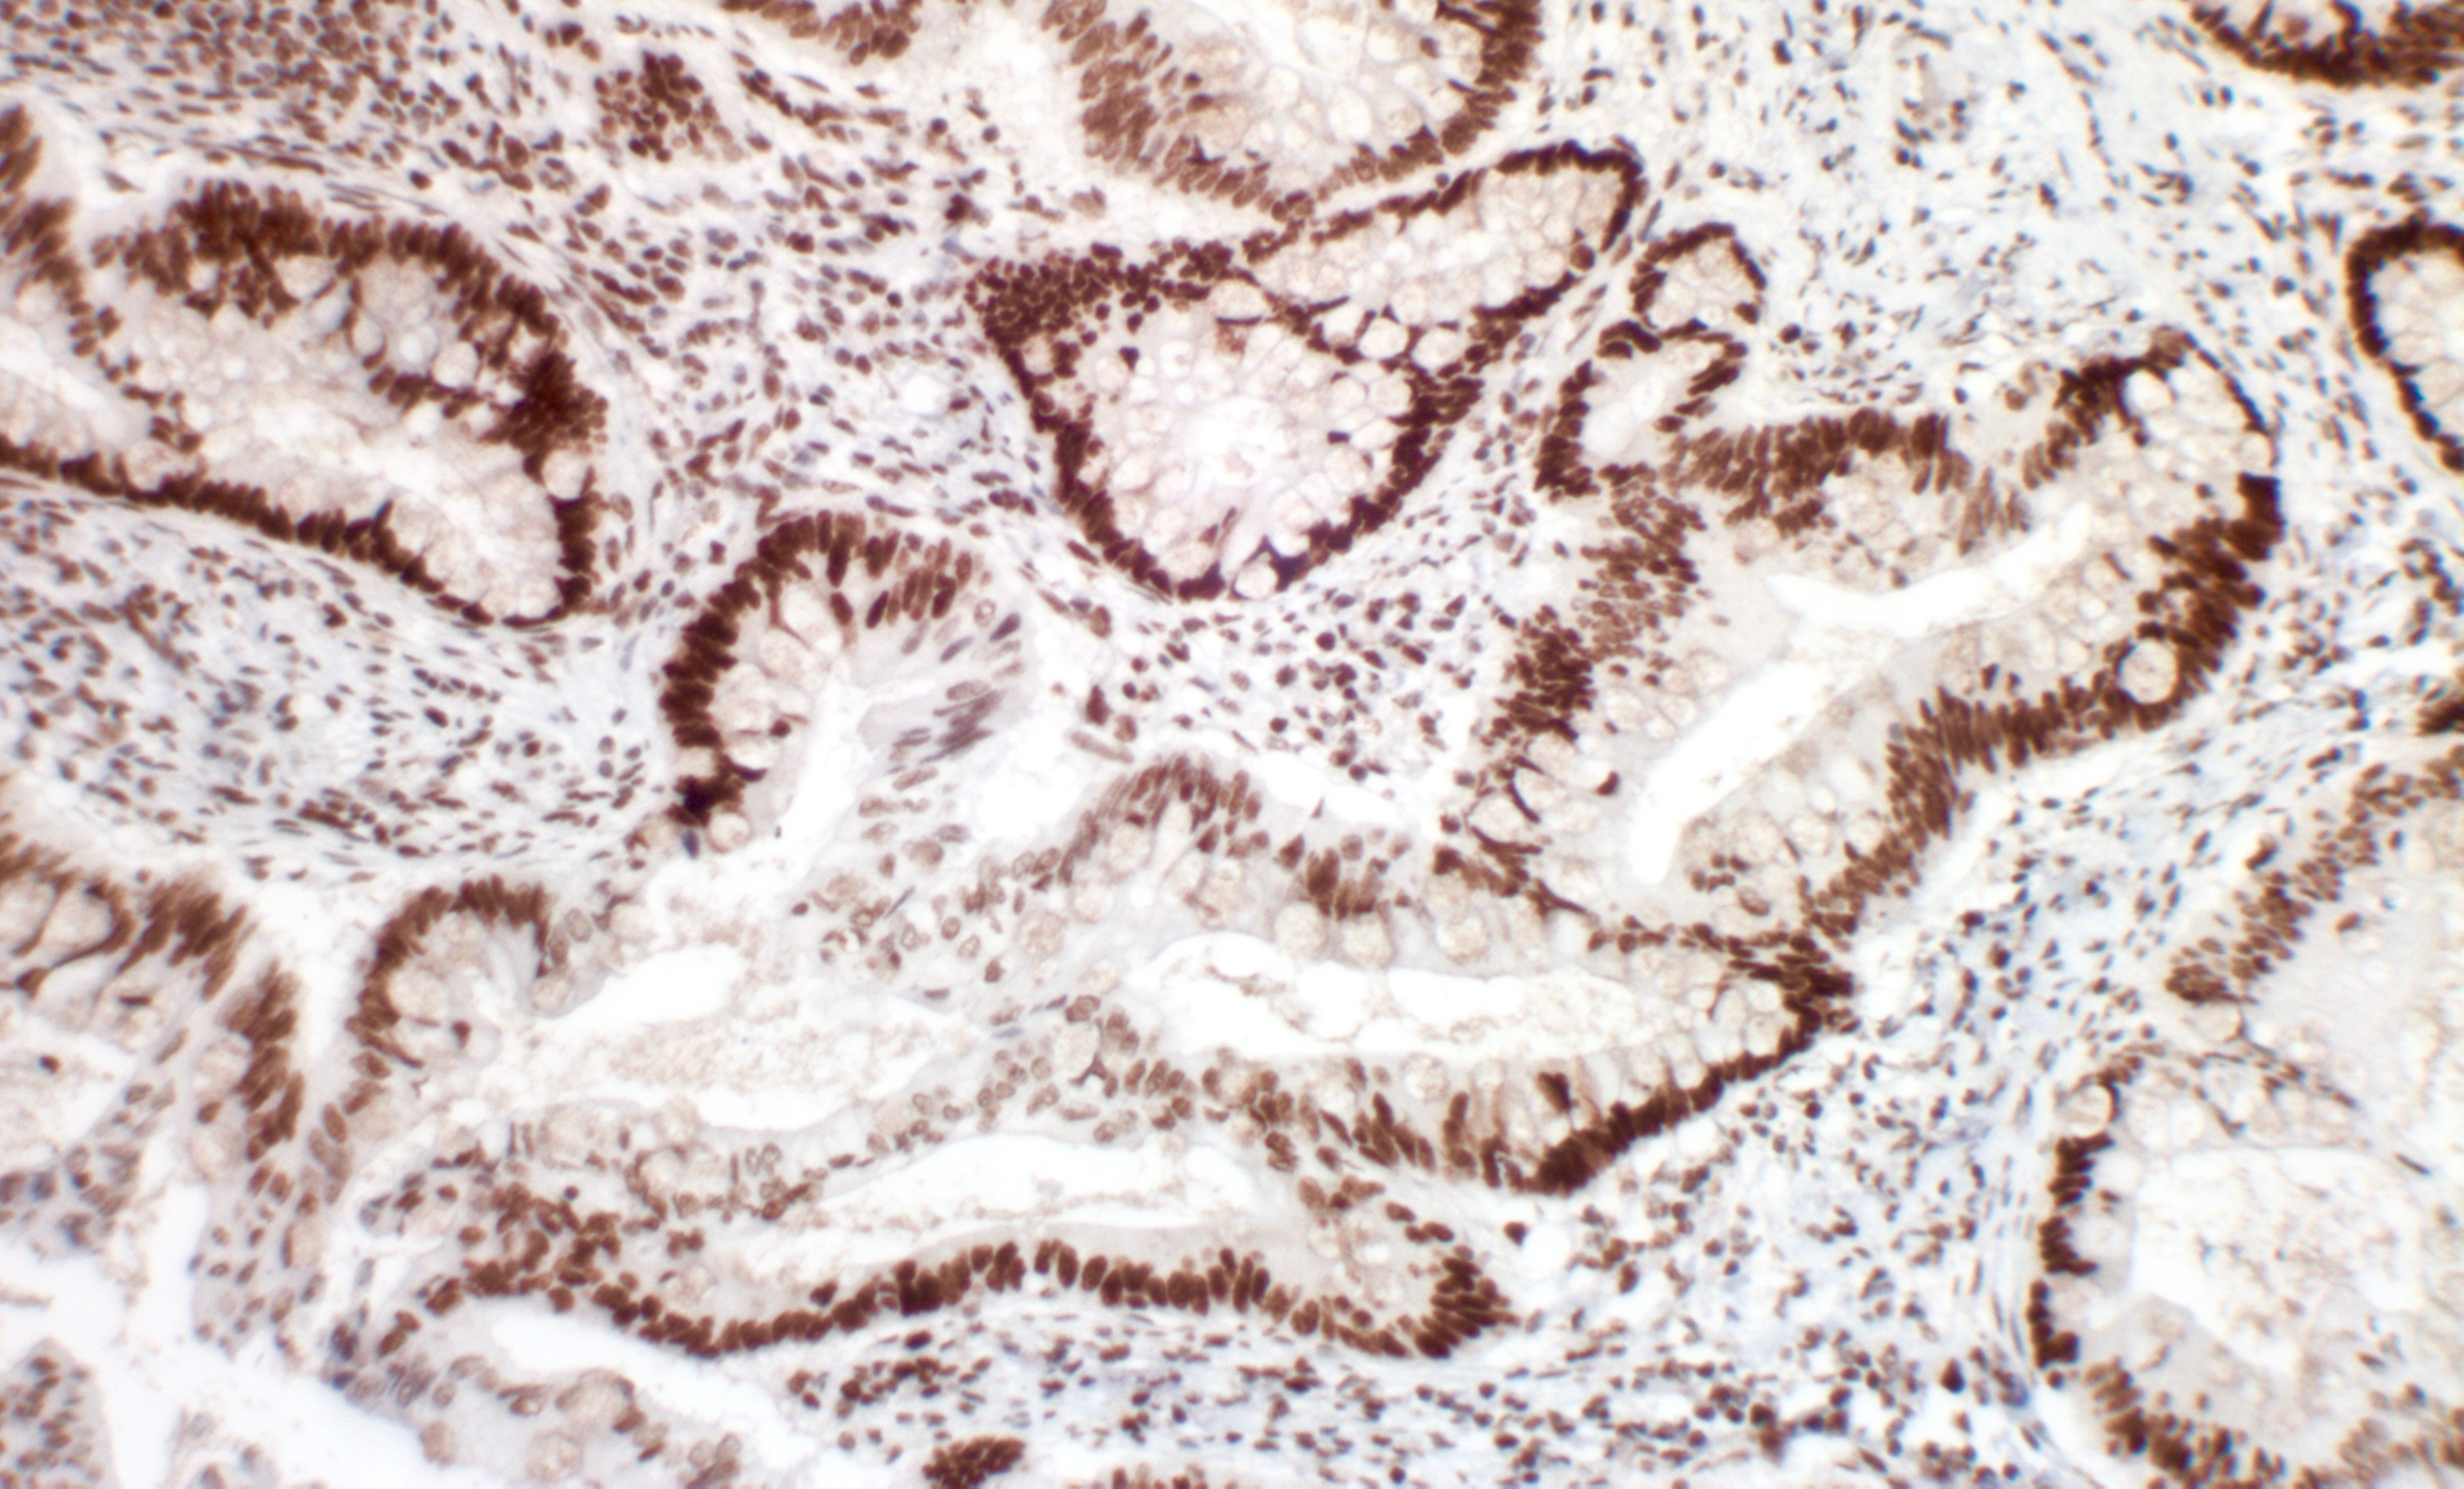

Pro PCR Kit
Polymerase Chain Reaction, most commonly known as PCR, is a technique based on the ability of DNA polymerase to synthesize complementary DNA strand to the given template strand. It allows amplification of very small sample or a short segment of DNA into millions and billions of copies rapidly. It is the most common and indispensable technique in a research and diagnostic laboratory.
Introduction
Polymerase Chain Reaction, most commonly known as PCR, is a technique based on the ability of DNA polymerase to synthesize complementary DNA strand to the given template strand. It allows amplification of very small sample or a short segment of DNA into millions and billions of copies rapidly. It is the most common and indispensable technique in a research and diagnostic laboratory.
Description
Ordering Information
| Catalog | Reactions |
|---|---|
| PA388-1 | 30 |
| PA486-0.1 | 89 |
| PA319-1 | 67 |
Documents
No documents available.